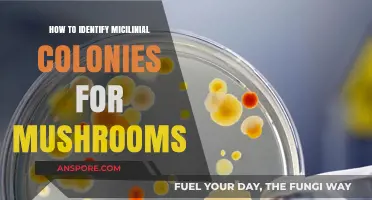
Identifying Mycelial Colonies: A Beginner's Guide to Mushroom Cultivation

Identifying mushrooms in the Black Hills requires a keen eye, patience, and knowledge of the region's diverse fungal species. The Black Hills, known for their unique ecosystem, host a variety of mushrooms, from edible delicacies like morels and chanterelles to toxic species such as the destroying angel. To safely identify mushrooms, start by observing key features: note the cap's shape, color, and texture, the presence or absence of gills, pores, or spines, and the stem's characteristics, including its height, width, and any rings or volvas. Additionally, consider the mushroom's habitat—whether it grows on wood, soil, or in symbiotic relationships with trees—as this can provide crucial clues. Always use a reliable field guide or consult with local mycological experts, and remember, when in doubt, leave it out, as misidentification can have serious consequences.
Explore related products
What You'll Learn
- Key physical features: Cap shape, gill structure, spore color, stem characteristics, and mushroom size
- Habitat clues: Soil type, tree associations, moisture levels, elevation, and sunlight exposure
- Seasonal patterns: Spring, summer, fall, and winter fruiting times for common species
- Toxic vs. edible: Identifying poisonous traits, look-alikes, and safe consumption guidelines
- Field guide usage: Best resources, apps, and local expert recommendations for accurate identification

Key physical features: Cap shape, gill structure, spore color, stem characteristics, and mushroom size
When identifying mushrooms in the Black Hills, cap shape is one of the most critical physical features to observe. Caps can vary widely, from convex (rounded like a dome) to planar (flat) or even depressed (funnel-shaped). Some mushrooms have caps that start convex and flatten with age. Pay attention to the margin (edge) of the cap—it can be smooth, wavy, or even rolled inward. Certain species, like the iconic Amanita, often have a distinctive shape that aids in identification. Always note the cap’s texture, which can range from smooth and shiny to scaly or fibrous, as this can be a key distinguishing factor.
Gill structure is another essential feature for mushroom identification. Gills are the thin, blade-like structures under the cap where spores are produced. Observe whether the gills are attached to the stem (adnate), free from it, or notched. The spacing between gills—whether they are close together or widely spaced—is also important. Some mushrooms, like the Chanterelles, have forked or wrinkled gills (technically called "ridges and forks"), which set them apart from other species. The color of the gills can change with age, so note their initial color and any changes over time.
Spore color is a microscopic but crucial feature for accurate identification. While you can’t see spores with the naked eye, you can determine their color by taking a spore print. Place the cap gills-down on a piece of paper or glass and leave it for several hours. The spores will drop and leave a colored deposit. Spore colors range from white and cream to pink, brown, black, or even purple. For example, Amanita mushrooms often have white spores, while many Lactarius species have creamy or yellowish spores. Spore color is a definitive characteristic used in mushroom taxonomy.
Stem characteristics provide additional clues for identification. Note the stem’s shape—whether it’s cylindrical, bulbous at the base, or tapering. The surface texture is also important; stems can be smooth, fibrous, or even slimy. Some mushrooms have a partial veil (a membrane that connects the cap to the stem) that leaves a ring (annulus) on the stem as the cap expands. Others may have a universal veil that leaves patches or a cup-like structure (volva) at the base. The stem’s color, firmness, and whether it bruises when touched are all valuable details to record.
Finally, mushroom size is a straightforward but important feature. Measure the cap’s diameter and the stem’s length and thickness. Sizes can range from tiny (less than an inch) to large (over 12 inches in diameter for some species). For example, the giant puffball (*Calvatia gigantea*) can grow to impressive sizes, while the delicate coral mushrooms (*Ramaria* species) are often smaller and branching. Always consider size in conjunction with other features, as some mushrooms have significant variability within a species. Keeping a field guide or using a mushroom identification app can help you compare your findings to known species in the Black Hills region.
Mushroom Roots: Supercharging Your Immune System
You may want to see also

Habitat clues: Soil type, tree associations, moisture levels, elevation, and sunlight exposure
When identifying mushrooms in the Black Hills, understanding their habitat is crucial. Soil type plays a significant role in determining which mushroom species thrive in a particular area. The Black Hills region features a variety of soil types, including sandy loams, clay-rich soils, and rocky substrates. For instance, morel mushrooms often prefer disturbed soils, such as those found in recently burned areas or along riverbanks, where the soil is rich in organic matter. Chanterelles, on the other hand, are commonly found in well-drained, acidic soils under coniferous trees. Observing the soil composition can narrow down the possibilities and guide your identification process.
Tree associations are another critical habitat clue in the Black Hills. Many mushrooms form mycorrhizal relationships with specific tree species, meaning they rely on these trees for nutrients. For example, pine trees are often associated with species like the pine mushroom (*Tricholoma magnivelare*), while aspen and birch trees may host species like the velvet foot (*Flammulina velutipes*). In the Black Hills, where ponderosa pines dominate, you’re more likely to find mushrooms that have adapted to this environment. Take note of the surrounding trees and their health, as this can provide valuable insights into the types of mushrooms present.
Moisture levels are essential for mushroom growth, and the Black Hills’ varied climate offers diverse conditions. Mushrooms typically require consistent moisture to fruit, so areas with higher humidity or recent rainfall are prime hunting grounds. Look for mushrooms near streams, in low-lying areas, or on north-facing slopes where moisture is retained longer. Conversely, some species, like the dryad's saddle (*Polyporus squamosus*), can tolerate drier conditions and may be found on decaying wood in less moist environments. Monitoring local weather patterns and seeking out damp habitats can significantly improve your chances of finding mushrooms.
Elevation influences temperature, humidity, and vegetation, all of which affect mushroom distribution in the Black Hills. Higher elevations tend to be cooler and moister, favoring species like the slippery jack (*Suillus luteus*), often found under spruce trees. Lower elevations, with their warmer temperatures, may host different species such as the oyster mushroom (*Pleurotus ostreatus*). Elevation also correlates with specific forest types; for instance, mixed conifer forests at mid-elevations are ideal for a variety of mycorrhizal mushrooms. Always consider the elevation when identifying mushrooms, as it can help you match species to their preferred habitats.
Sunlight exposure is the final piece of the habitat puzzle. Mushrooms generally prefer shaded environments, as direct sunlight can dry them out quickly. In the Black Hills, south-facing slopes receive more sunlight and are often drier, while north-facing slopes retain moisture and provide the shaded conditions many mushrooms need. Look for mushrooms in areas with filtered or dappled sunlight, such as under dense canopies or near the base of trees. Some species, like the sulfur shelf (*Laetiporus sulphureus*), can tolerate more light but still thrive in partially shaded areas. Paying attention to sunlight exposure will help you locate mushrooms and understand their ecological preferences.
By carefully observing these habitat clues—soil type, tree associations, moisture levels, elevation, and sunlight exposure—you can significantly enhance your ability to identify mushrooms in the Black Hills. Each of these factors provides valuable context, allowing you to narrow down possibilities and make more accurate identifications. Remember, mushrooms are highly adapted to their environments, so understanding their habitat is key to successful foraging and identification.
Understanding Tree Base Fungi: What Are Mushrooms Growing at Tree Roots Called?
You may want to see also

Seasonal patterns: Spring, summer, fall, and winter fruiting times for common species
The Black Hills region offers a diverse array of mushroom species, each with distinct fruiting patterns tied to seasonal changes. Understanding these seasonal patterns is crucial for accurate identification and foraging. Spring marks the beginning of mushroom activity in the Black Hills, as the snow melts and temperatures rise. One of the earliest species to appear is the Morel mushroom (*Morchella* spp.), a highly prized edible fungus. Morels typically fruit in April and May, favoring deciduous woodlands and areas with recent disturbances like wildfires. Another spring fruiter is the Pheasant Back Mushroom (*Polyporus arcularius*), which grows on decaying wood and can be identified by its fan-like shape and brown, scaly cap. Spring foragers should also look for Oyster Mushrooms (*Pleurotus ostreatus*), which often appear on dead or dying hardwood trees during this season.
As temperatures warm, summer brings a shift in fruiting patterns, with many species thriving in the increased moisture and heat. The Chanterelle (*Cantharellus cibarius*) is a standout summer mushroom, fruiting from June through August in coniferous and mixed forests. Its golden color and forked gills make it relatively easy to identify. Another common summer species is the Lions Mane (*Hericium erinaceus*), which grows on hardwood trees and is recognizable by its cascading, icicle-like spines. Foragers should also be cautious of the False Morel (*Gyromitra esculenta*), which fruits in summer and resembles true morels but is toxic if not prepared properly. Summer rains often trigger fruiting in Russula and Lactarius species, which are abundant in the Black Hills but require careful identification due to their varied edibility.
Fall is arguably the most prolific season for mushroom fruiting in the Black Hills, as cooler temperatures and increased rainfall create ideal conditions. The Porcini or King Bolete (*Boletus edulis*) is a highly sought-after fall species, found under conifers and identifiable by its spongy pores and robust stature. Hedgehogs (*Hydnum repandum*) also fruit in the fall, distinguished by their tooth-like spines instead of gills. Foragers should be aware of the Amanita genus, which includes both edible species like the Amanita muscaria and toxic varieties like the Destroying Angel (*Amanita bisporigera*). Fall is also the prime time for Turkey Tail (*Trametes versicolor*), a medicinal mushroom that grows on decaying wood and displays vibrant, banded colors.
Winter is the least active season for mushroom fruiting in the Black Hills, but a few hardy species still emerge. The Velvet Foot (*Flammulina velutipes*) is a winter mushroom that grows on dead hardwood trees and is recognizable by its bright orange cap and ability to withstand freezing temperatures. Another winter fruiter is the Witch's Butter (*Exidia glandulosa*), a jelly-like fungus that appears on branches and logs. While winter foraging is less common, these species highlight the year-round nature of mushroom growth in the region. Understanding these seasonal patterns not only aids in identification but also ensures sustainable foraging practices by respecting the natural cycles of these fungi.
Shiitake Mushrooms: Healthy Superfood or Overhyped Fungi?
You may want to see also
Explore related products
$16.63 $20

Toxic vs. edible: Identifying poisonous traits, look-alikes, and safe consumption guidelines
When foraging for mushrooms in the Black Hills, distinguishing between toxic and edible species is crucial for your safety. One of the first steps is to familiarize yourself with common poisonous traits. Many toxic mushrooms, such as the Amanita genus, have distinct characteristics like a bulbous base, a ring on the stem, and gills that are often white or closely spaced. For example, the Death Cap (*Amanita phalloides*) and Destroying Angel (*Amanita bisporigera*) are deadly look-alikes of edible mushrooms like the Paddy Straw mushroom. Always avoid mushrooms with these features unless you are absolutely certain of their identity. Additionally, toxic mushrooms often have a pungent or unpleasant odor, while edible ones typically smell mild or earthy.
Edible mushrooms in the Black Hills, such as the Morel (*Morchella* spp.) and Chanterelle (*Cantharellus* spp.), have unique features that set them apart from their toxic counterparts. Morels, for instance, have a honeycomb-like cap and are hollow, while false morels (which can be toxic) are often wrinkled or brain-like and are not hollow. Chanterelles have forked gills and a fruity aroma, whereas their look-alike, the Jack-O-Lantern mushroom (*Omphalotus olearius*), has true gills and a sharp, unpleasant smell. Always cross-reference multiple field guides or apps to confirm identification, as relying on a single characteristic can be misleading.
Look-alike mushrooms are a common pitfall for foragers. For example, the edible Lion’s Mane (*Hericium erinaceus*) can be confused with the toxic False Lion’s Mane (*Dentipellis fragilis*), which has a similar appearance but grows on wood and lacks the edible species’ cascading spines. Another dangerous pair is the edible Shaggy Mane (*Coprinus comatus*) and the toxic Inky Cap (*Coprinopsis atramentaria*), which can cause severe reactions when consumed with alcohol. To avoid mistakes, examine details like spore color (by placing the cap on paper overnight), habitat, and seasonality, as these can differ significantly between toxic and edible species.
Safe consumption guidelines are essential even after proper identification. Always cook wild mushrooms thoroughly, as some edible species can cause digestive issues when raw. Start by consuming a small amount of a new species to test for allergic reactions. Avoid foraging in areas contaminated by pollutants, such as roadsides or industrial sites, as mushrooms absorb toxins from their environment. Finally, never eat a mushroom unless you are 100% certain of its identity. When in doubt, throw it out—the risk of poisoning is not worth the reward.
Joining local mycological clubs or workshops in the Black Hills can provide hands-on experience and expert guidance. These groups often organize foraging trips and offer resources for identifying regional species. Remember, mushroom identification is a skill that develops over time with practice and patience. Always carry a notebook to document your findings, including photos, descriptions, and locations, to improve your knowledge and contribute to the broader foraging community. By combining careful observation, education, and caution, you can safely enjoy the bounty of edible mushrooms in the Black Hills while avoiding their toxic counterparts.
Blessing for Mushrooms: What's the Right Bracha?
You may want to see also

Field guide usage: Best resources, apps, and local expert recommendations for accurate identification
When venturing into the Black Hills to identify mushrooms, utilizing a reliable field guide is essential. Field guides specifically tailored to the region, such as *Mushrooms of the Rocky Mountain Region* by Vera Evenson, are invaluable. This guide includes detailed descriptions, color photographs, and distribution maps, making it easier to match findings to known species. Another highly recommended resource is *National Audubon Society Field Guide to North American Mushrooms*, which, while broader in scope, covers many species found in the Black Hills. These guides provide critical information on morphology, habitat, and edibility, though it’s important to cross-reference findings with multiple sources to avoid misidentification.
In addition to physical guides, mobile apps have become indispensable tools for mushroom identification. Apps like *PictureThis - Plant Identifier* and *Mushroom Identifier* use AI to analyze photos and provide potential matches. However, for the Black Hills specifically, *iNaturalist* stands out as a top choice. This app not only helps identify mushrooms but also connects users with a community of naturalists and mycologists who can verify findings. When using apps, ensure you take clear, well-lit photos of the mushroom’s cap, gills, stem, and base, as these details are crucial for accurate identification.
For those seeking hands-on learning, local expert recommendations are invaluable. The Black Hills Mushroom Club organizes foraging trips and workshops led by experienced mycologists who can provide real-time identification guidance. Additionally, reaching out to local universities, such as South Dakota School of Mines and Technology, may connect you with faculty or students specializing in mycology. Attending regional foraging events or workshops can also enhance your skills, as experts often share tips on distinguishing look-alike species and understanding the unique fungal ecosystems of the Black Hills.
Combining field guides, apps, and local expertise creates a robust approach to mushroom identification. Always remember that safety is paramount—never consume a mushroom without 100% certainty of its edibility. Even with the best resources, consulting multiple sources and, when in doubt, avoiding consumption is the safest practice. By leveraging these tools and recommendations, you’ll be well-equipped to explore and identify the diverse mushroom species of the Black Hills accurately and responsibly.
Weed Killer vs Mushrooms: What Works?
You may want to see also
Frequently asked questions
Focus on the mushroom's cap shape, color, and texture; gill or pore structure; stem characteristics (including color, shape, and presence of a ring or volva); spore print color; and habitat (such as soil type, nearby trees, and elevation).
Yes, poisonous species like the Destroying Angel (*Amanita bisporigera*) and False Morel (*Gyromitra esculenta*) are present. Always consult a field guide or expert before consuming any wild mushrooms.
Spore print color is crucial as it helps differentiate between similar-looking species. To obtain a spore print, place the cap gills-down on paper overnight and observe the color left behind.
Late summer to early fall (August through October) is prime mushroom season in the Black Hills, as moisture and cooler temperatures promote fungal growth.
Yes, consider joining the Black Hills Mycological Society or attending local foraging workshops. Field guides specific to the region, such as *Mushrooms of the Rocky Mountain Region*, are also valuable tools.